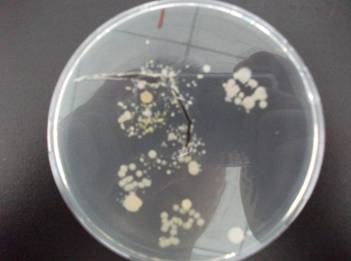

今年已经是第三年领冰冰参加中科院各研究所的开放日了。第一年,只是在声学所里随处转转,听了一个专门给小朋友准备的声音的讲座;第二年,去自动化所看了一下机器人和机器鱼,去物理所看了一下磁悬浮的火车模型,又来声学所里逛了一会。今年更忙了,居然连所里都没有时间来了,结果错过了3D电视、超声碎石、蝙蝠模型和声相仪这些好东西,怪只怪时间太有限,怪只怪新鲜东西越来越多。
往年大屯附近的研究所都比中关村的晚一个星期,可是今年安排在了一起,所以这个周末过得简直太充实了,马不停蹄呀。
冰冰前一阵一直问什么是微生物,对显微镜、环保低碳也很感兴趣,所以我在网上事先做足了功课,将有兴趣的研究所的开放日安排记录下来,以便有重点地参观。初步计划就是周六先去微生物所用光学显微镜观看微生物,了解一下到底什么是微生物,培养细菌看看,有时间再去地理所看节能减排;周日去物理所看电子显微镜和低温试验,有时间再来声学所。
周六一早我们首先来到动物所门口,拿了几个关于动物的宣传页,冰冰为了要一个风筝也抢着猜了一个谜语,因为动物博物馆已经去过两次了,所以我们就直奔微生物所。第一站是科普探索实验室,志愿者首先介绍了微生物的一些相关知识,然后让冰冰在培养基上留下自己手印,回头可以通过电子信箱收到培养出来的菌群照片。

志愿者耐心的讲解

冰冰听得多认真呀
冰冰手印培养出的菌群
只三天的功夫,细菌就长成这个样子了,看冰冰以后还敢不敢吃手了。
来到大厅显微镜操作平台,利用光学显微镜观察地衣和细菌,光学显微镜可以看到细菌,但是对病毒就无能为力了,所以我们在第二天的行程里安排了去物理所看电子显微镜,冰冰前一阵学习了一些显微镜的知识,所以对这些很感兴趣。事实上我们在物理所还有幸看到了扫描探针显微镜,这种显微镜比扫描隧道显微镜更厉害,可以很容易地看到原子等更微小的东西。
接着我们就随着清华生物系的学生一起来到了菌种保藏中心。这里有液氮和干燥两种环境,保存着很多珍贵的菌种,主要原理都是利用低温抑制细胞的新陈代谢来达到长久存储的目的。由于这里比较冷,而且都是盒盒罐罐,小朋友不是很感兴趣,冰冰就和小朋友早早地跑了。

液氮存储罐

低温干燥存储室

低温干燥保存的菌种
我们在真菌标本馆会合,发现小朋友都对摘蘑菇的那个游戏很感兴趣。在这里还看到了很多真菌的标本,比如灵芝、鸡枞、各种形态的地衣、蘑菇等等。微生物除了细菌、病毒这些需要借助显微镜才能看到的种类外,还有一类就是真菌,对于部分真菌肉眼就能看到为什么还算是微生物,只能从其本质上来区分了。
趁着还有时间,我们来到地理所。地理所的服务很值得称道,只要有四人以上就可以成团,全程陪同,不过也留给我们留了作业,就是要对他们的服务进行问卷调查,有小礼品赠送。冰冰最感兴趣的就是听节能减排的介绍,很认真,值得表扬。在观测站介绍的地方,发现冰冰爷爷家和鲁宁姥姥家的刚好摆在一起,这个小发现让两个小朋友都很兴奋;在三维地形展示中,虽然志愿者声明他们没有实地考察,但是冰冰还是一眼认出了早晨走过的在奥运公园下面的长长的隧道。另外,标示全国观测站的沙盘模型、用显微镜观看树轮、土壤修复实验室等处的参观也很有收获。当然,两个小朋友最喜欢的就是地理所外面的音乐喷泉,不过,这也让我们很懊恼功课做得还是不够好,没有给他们准备凉鞋。

认真学习节能减排的知识

这个喷泉真是不错
周日,我们来到物理所时,鲁宁已经早早地到了,我们等天天也到了,才开始我们的参观。今天因为新奇的东西比较多,所以光顾着听讲解,几乎忘了照相。
超导磁悬浮小车演示去年冰冰看得很痴迷,今年就没有在那里停留很长时间,所以我们才有机会把其他的地方走个差不多。一个小子晶经过7天,就长成下面这个样子了,实验室外面还摆了很多实物,和宝石一样很漂亮,可以以假乱真了。

晶体生长
高压热冰也很有意思,常温情况下通过加压就可以形成冰块,但是这种冰块和普通的冰块还是不一样,首先密度就不一样,那这两种冰块还是同一种物质吗?冰块能吃,这个能吃吗?
三个小朋友最感兴趣的就是我们的最后一站:低温试验。小金鱼放入液氮中几分钟后再放回水中,过了一会,又开始慢慢动起来了。新鲜的树叶放进去,一拿出来立刻用硬物敲击,马上就变成了碎片,如果不动慢慢还可以恢复。小朋友开始还不知道天高地厚地用手摸那个液氮挥发的白气,觉得很好玩,可一看到变成碎片的树叶,马上知道了厉害。
时间过得真快,我们都觉得这个开放日一年一次,一次还只有一天,时间实在是太少太短了,应该每学期办一次,一次两天,不然根本逛不过来。
今年错过了声学所的很多东西,明年如果还只有一天,我决定就带冰冰这几个小朋友在声学所逛了,希望明年可以看到更多的好东西。



